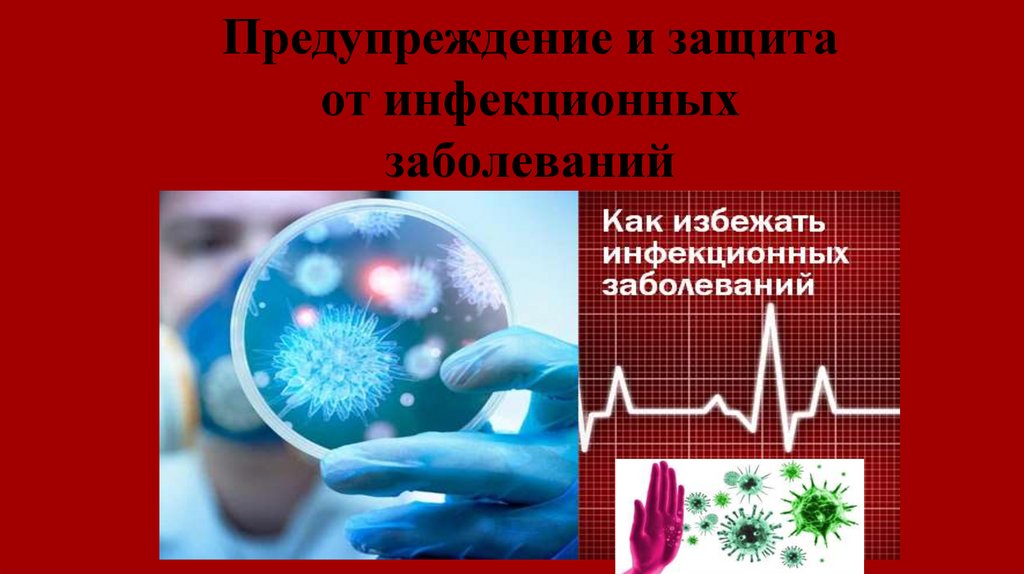

Similar presentations:
9-11_Предупреждение и защита от инфекционных заболеваний
1. Предупреждение и защита от инфекционных заболеваний
2.
3.
4.
Виды инфекционных заболеваний1. Кишечные
инфекции
2. Кровяные
инфекции
3. Инфекции
дыхательных
путей
4. Инфекции
наружных
покровов
5.
6.
7.
8.
9.
10.
11.
12.
13.
14.
15.
16.
17.
18.
19.
20.
21.
22.
23. Проверочные вопросы для самоконтроля
1.2.
3.
4.
5.
6.
7.
Кишечная инфекция, заболевание грязных рук.
Заболевание от употребления недоброкачественных продуктов.
Обработка всех предметов и жилья, которыми пользовался инфекционный больной.
Инъекция (укол) от инфекционного заболевания для выработки иммунитета.
Вирусное заболевание, поражающее печень.
Массовое заболевание населения инфекционными болезнями.
Инфекционное кожное заболевание, вызывающее сильный зуд.
24. Ответы на вопросы
1.2.
3.
4.
5.
6.
7.
Дизентерия
Ботулизм
Дезинфекция
Прививка
Гепатит
Эпидемия
Чесотка